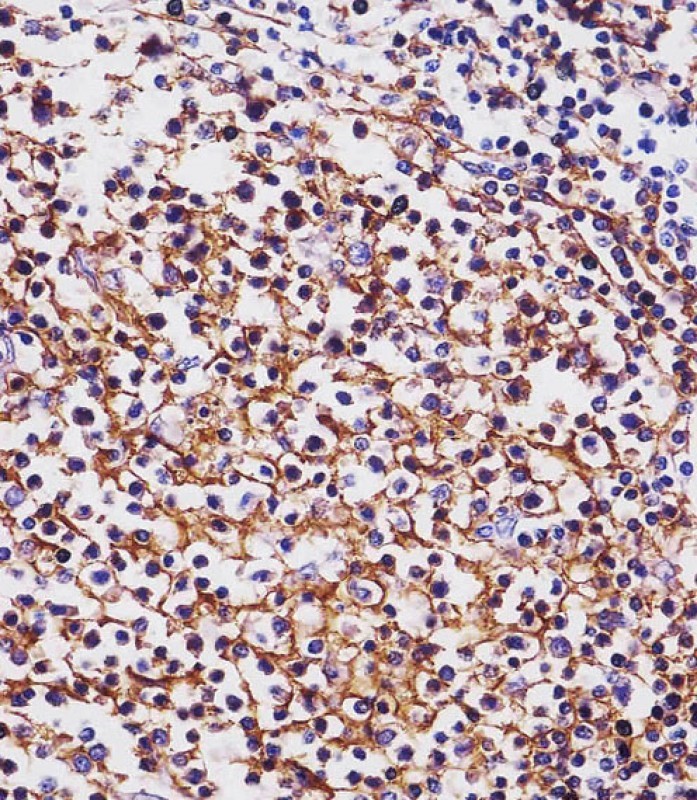

别名:B-lymphocyte antigen CD20, B-lymphocyte surface antigen B1, Bp35, Leukocyte surface antigen Leu-16, Membrane-spanning 4-domains subfamily A member 1, CD20, MS4A1, CD20应用:WB,IHC
反应种属:Human
规格:50μl/100μl
| Description |
|---|
| This gene encodes a member of the membrane-spanning 4A gene family. Members of this nascent protein family are characterized by common structural features and similar intron/exon splice boundaries and display unique expression patterns among hematopoietic cells and nonlymphoid tissues. This gene encodes a B-lymphocyte surface molecule which plays a role in the development and differentiation of B-cells into plasma cells. This family member is localized to 11q12, among a cluster of family members. Alternative splicing of this gene results in two transcript variants which encode the same protein. |
| Specification | |
|---|---|
| Aliases | B-lymphocyte antigen CD20, B-lymphocyte surface antigen B1, Bp35, Leukocyte surface antigen Leu-16, Membrane-spanning 4-domains subfamily A member 1, CD20, MS4A1, CD20 |
| Entrez GeneID | 931 |
| Swissprot | P11836 |
| WB Predicted band size | 33.1kDa |
| Host/Isotype | Mouse IgG1 |
| Storage | Store at 4°C short term. Aliquot and store at -20°C long term. Avoid freeze/thaw cycles. |
| Species Reactivity | Human |
| Immunogen | This MS4A1/CD20 antibody is generated from mice immunized with a KLH conjugated synthetic peptide between 266-294 amino acids from the C-terminal region of human MS4A1/CD20. |
| Formulation | Purified monoclonal antibody supplied in PBS with 0.05% sodium azide. This antibody is prepared by Saturated Ammonium Sulfate (SAS) precipitation followed by dialysis against PBS. |
| Application | |
|---|---|
| WB | 1/500-1/1000 |
| IHC | 1/100-1/1000 |
![]() |
MS4A1/CD20 Antibody (C-term) (Cat. #P31691) western blot analysis in Ramos cell line lysates (35μg/lane).This demonstrates the MS4A1/CD20 antibody detected the MS4A1/CD20 protein (arrow). |
![]() |
P31691 staining MS4A1/CD20 in human tonsil tissue sections by Immunohistochemistry (IHC-P – paraformaldehyde-fixed, paraffin-embedded sections). Tissue was fixed with formaldehyde and blocked with 3% BSA for 0. 5 hour at room temperature; antigen retrieval was by heat mediation with a citrate buffer (pH6). Samples were incubated with primary antibody (1/100) for 1 hours at 37°C. A undiluted biotinylated goat polyvalent antibody was used as the secondary antibody. |
![]() |
Immunohistochemical analysis of paraffin-embedded Human tonsil section using Pink1(Cat#P31691). P31691 was diluted at 1:1000 dilution. A undiluted biotinylated goat polyvalent antibody was used as the secondary, followed by DAB staining. |
本公司的所有产品仅用于科学研究或者工业应用等非医疗目的,不可用于人类或动物的临床诊断或治疗,非药用,非食用。
暂无评论
本公司的所有产品仅用于科学研究或者工业应用等非医疗目的,不可用于人类或动物的临床诊断或治疗,非药用,非食用。
中文

发表回复